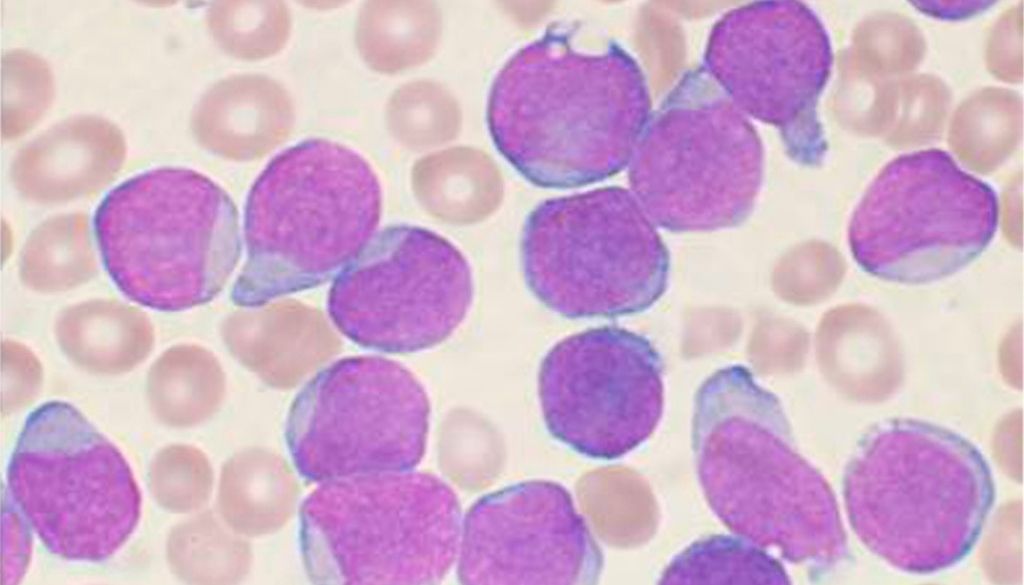

Fármacos biotecnológicos e inmunoterapia mejoran la eficiencia del tratamiento contra la leucemia

La detección temprana de la leucemia linfoblástica aguda (LLA) y el uso de fármacos biotecnológicos están transformando el tratamiento de este tipo de cáncer, afirmó el oncólogo pediatra Alberto Olaya durante la XII Cumbre de Excelencia Médica Amgen (CEMA 2025). “El diagnóstico oportuno es el primer paso; cuanto más temprano se detecta, más eficiente es […]
Diagnóstico temprano y terapia personalizada puede aumentar cura de la leucemia hasta un 90 %

“Si tú tienes acceso a un hospital, a un especialista en esta área, te hacen un diagnóstico oportuno y te dan un tratamiento específico con medicamentos de vanguardia, la supervivencia de esta leucemia puede ser hasta del 90 % (…) Eso marca la diferencia en la supervivencia”, reconoció la especialista tras su participación en la […]
Una inmunoterapia mejora a bebés con leucemia muy agresiva

Un ensayo con una treintena de pacientes menores de un año constata que añadir un anticuerpo biespecífico al tratamiento de quimioterapia habitual eleva del 66% al 93% la supervivencia en un subtipo de tumor de la sangre. El cáncer en los niños es una enfermedad considerada rara, muy poco frecuente: apenas 155 casos nuevos al […]
Descubren rol de proteína clave en el desarrollo leucemia mielogénica crónica
Investigadores han descubierto que la proteína SOS1 es necesaria para desarrollar leucemia mielogénica crónica, un tipo de cáncer en el que la médula ósea produce demasiados glóbulos blancos. El hallazgo del equipo liderado por el Consejo Superior de Investigaciones Científicas (CSIC) ofrece una vía novedosa en el diseño de nuevos fármacos que podrían ser útiles […]
Los científicos desarrollan una nueva clase de fármaco contra el cáncer con potencial para tratar la leucemia

Los científicos de la Universidad de Cambridge (Reino Unido) han dado un paso prometedor hacia el desarrollo de un nuevo fármaco para tratar la leucemia mieloide aguda. En un estudio publicado en la revista ‘Nature’, informan de un nuevo enfoque para el tratamiento del cáncer que se dirige a las enzimas que desempeñan un papel […]
